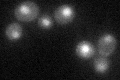
YML060W

View description
Mitochondrial glycosylase/lyase that specifically excises 7,8-dihydro-8-oxoguanine residues located opposite cytosine or thymine residues in DNA, repairs oxidative damage to mitochondrial DNA, contributes to UVA resistance
Localization:
Intensity:
Fold change:
Significance:
-
C’ GFP library in SD
nucleus23.47 -
N' NOP1pr-GFP in SD

nucleus75.891 -
N' TEF2pr-mCherry in SD

nucleus19.2467 -
N' NATIVEpr-GFP in SD

nucleus21.9505 -
N' TEF2pr-VC and Cyto-VN in SD

#N/A0 -
C’ GFP library in SD+DTT

nucleus18.780.79Yes -
C’ GFP library in SD+H2O2

nucleus23.260.99No -
C’ GFP library in Starvation Media

nucleus27.441.16No -
C’ GFP library on the background of Pup2-DaMP

N/A -
C’ GFP library on the background of CCT mutant

N/A0N/AYes
